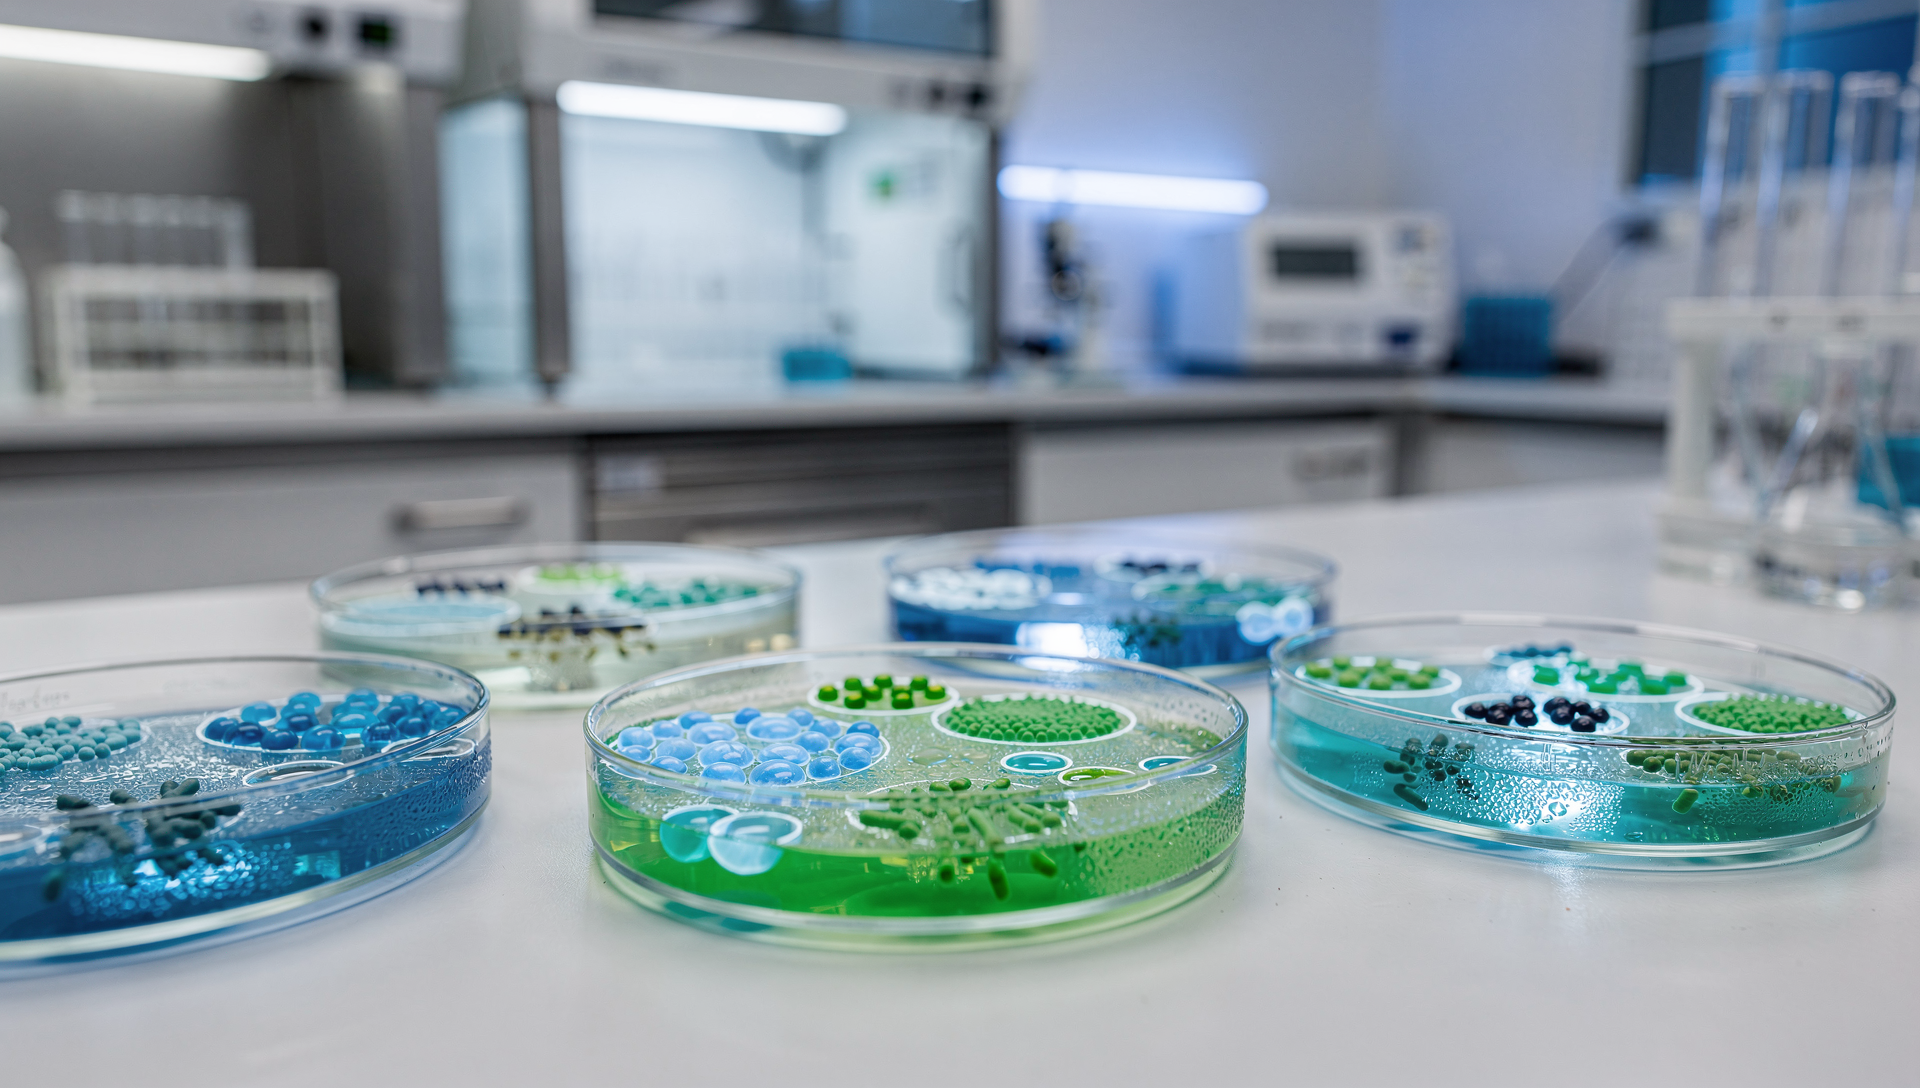
Wissenschaftliche Forschung zu Probiotika im Labor mit Bakterienkulturen

Kurz & Knapp: Fermentierte Lebensmittel entstehen durch die kontrollierte Umwandlung von Nahrungsmitteln durch Mikroorganismen wie Bakterien, Hefen oder Schimmelpilze. Diese jahrtausendealte Konservierungsmethode reichert Lebensmittel mit lebenden Kulturen, Vitaminen und bioaktiven Verbindungen an. Zu den bekanntesten fermentierten Lebensmitteln zählen Sauerkraut, Kimchi, Joghurt, Kefir, Kombucha, Miso, Tempeh und Sauerteigbrot.

Fermentierte Lebensmittel erleben gerade eine Renaissance – und das aus gutem Grund. Was unsere Vorfahren aus purer Notwendigkeit zur Konservierung entwickelten, erweist sich heute als Schlüssel für eine gesunde Darmflora und ein starkes Immunsystem.
In diesem umfassenden Guide findest du über 50 fermentierte Lebensmittel aus aller Welt, erfährst, welche Vorteile sie bieten und wie du sie ganz einfach in deinen Alltag integrieren kannst.
📋 Inhaltsverzeichnis
Was ist Fermentation?
Fermentation ist ein biochemischer Umwandlungsprozess, bei dem Mikroorganismen organische Stoffe abbauen und dabei neue Verbindungen entstehen. Je nach Art der beteiligten Mikroorganismen unterscheidet man verschiedene Fermentationsarten:

🥬 Milchsäuregärung
Mikroorganismen: Lactobacillus, Leuconostoc
Beispiele: Sauerkraut, Kimchi, Joghurt, Kefir
Endprodukt: Milchsäure (pH-Senkung)
🍺 Alkoholische Gärung
Mikroorganismen: Saccharomyces (Hefen)
Beispiele: Bier, Wein, Brot
Endprodukt: Ethanol + CO2
🧀 Essigsäuregärung
Mikroorganismen: Acetobacter
Beispiele: Essig, Kombucha
Endprodukt: Essigsäure
🍄 Schimmelpilz-Fermentation
Mikroorganismen: Aspergillus, Rhizopus
Beispiele: Tempeh, Miso, Koji
Endprodukt: Enzyme, Umami
„Die Milchsäuregärung ist der sicherste Einstieg für Fermentations-Anfänger. Das saure Milieu verhindert zuverlässig das Wachstum schädlicher Bakterien – vorausgesetzt, das Gemüse bleibt vollständig unter der Lake."
— Aus der HeldenPilz Werkstatt
Die Vorteile fermentierter Lebensmittel
Die wissenschaftliche Forschung hat in den letzten Jahren zahlreiche Vorteile fermentierter Lebensmittel bestätigt. Hier sind die wichtigsten:
Lebende Kulturen
Milliarden probiotischer Bakterien, die deine Darmflora unterstützen können
Bessere Bioverfügbarkeit
Nährstoffe werden durch Fermentation besser aufnehmbar
Vitamin-Synthese
B-Vitamine und Vitamin K werden während der Fermentation gebildet
Antinährstoffe abgebaut
Phytinsäure und andere Antinährstoffe werden reduziert
Längere Haltbarkeit
Natürliche Konservierung ohne künstliche Zusätze
Komplexer Geschmack
Umami und neue Aromen entstehen durch mikrobielle Aktivität
📊 Was die Wissenschaft sagt
Eine Meta-Analyse aus 2014 im Journal "Nutrition Research" wertete 34 Studien aus und kam zu dem Schluss, dass der regelmäßige Verzehr fermentierter Milchprodukte mit probiotischen Kulturen positive Effekte auf verschiedene Gesundheitsmarker haben kann.
Milchsauer fermentiertes Gemüse
Die Milchsäuregärung ist die älteste und verbreitetste Form der Gemüsefermentation. Dabei wandeln Lactobacillus-Bakterien natürlichen Zucker in Milchsäure um, was den pH-Wert senkt und das Gemüse haltbar macht.

🥬 Die wichtigsten milchsauer fermentierten Gemüse
Sauerkraut (Deutschland)
Basis: Weißkohl + Salz
Fermentationszeit: 3-6 Wochen
Besonderheit: Reich an Vitamin C, Vitamin K
Kimchi (Korea)
Basis: Chinakohl + Gochugaru + Fischsauce
Fermentationszeit: 1-4 Wochen
Besonderheit: Über 200 verschiedene Sorten
Salzgurken (Osteuropa)
Basis: Gurken + Salzlake + Dill
Fermentationszeit: 1-4 Wochen
Besonderheit: Nicht pasteurisiert = lebendig
Curtido (El Salvador)
Basis: Kohl + Karotten + Oregano
Fermentationszeit: 1-3 Tage
Besonderheit: Schnellfermentiert, knackig
Tsukemono (Japan)
Basis: Diverse Gemüse + Reiskleie
Fermentationszeit: Stunden bis Monate
Besonderheit: Viele verschiedene Techniken
Torshi (Naher Osten)
Basis: Mixed Pickles + Essig + Gewürze
Fermentationszeit: 2-4 Wochen
Besonderheit: Traditionelle Mezze-Beilage
➕ Weitere milchsauer fermentierte Gemüsesorten:
Fermentierte Möhren Rote Bete Kwas Fermentierter Knoblauch Eingelegte Zwiebeln Fermentierter Rettich Sauerbohnen Fermentierte Paprika Fermentierte Tomaten Fermentierte Chilis Pak Dong (Thailand)
Fermentierte Milchprodukte
Fermentierte Milchprodukte gehören zu den ältesten und am weitesten verbreiteten fermentierten Lebensmitteln. Sie entstehen durch die Aktivität von Milchsäurebakterien und teilweise auch Hefen.

🥛 Joghurt
Kulturen: L. bulgaricus, S. thermophilus
Herkunft: Zentralasien / Bulgarien
Nährstoff-Highlight: Calcium, Protein
🥛 Kefir
Kulturen: 30-60 verschiedene Stämme
Herkunft: Kaukasus
Nährstoff-Highlight: B12, Biotin, Folsäure
🥛 Buttermilch
Kulturen: L. lactis, L. cremoris
Herkunft: Europa
Nährstoff-Highlight: Kalium, fettarm
🥛 Skyr (Island)
Kulturen: Spezielle Skyr-Kulturen
Herkunft: Island (Wikinger)
Nährstoff-Highlight: Sehr proteinreich
🥛 Labneh (Naher Osten)
Kulturen: Joghurt-Kulturen, abgetropft
Herkunft: Levante
Nährstoff-Highlight: Cremig, proteinreich
🥛 Ayran (Türkei)
Kulturen: Joghurt + Wasser + Salz
Herkunft: Türkei / Zentralasien
Nährstoff-Highlight: Elektrolyte, erfrischend
➕ Weitere fermentierte Milchprodukte weltweit:
Lassi (Indien) Doogh (Iran) Filmjölk (Schweden) Viili (Finnland) Kumis (Zentralasien) Crème fraîche Saure Sahne Quark
Fermentierte Getränke
Fermentierte Getränke reichen von alkoholfreien Probiotika-Drinks bis zu traditionellen alkoholischen Getränken. Der gemeinsame Nenner: Lebendige Mikroorganismen transformieren einfache Zutaten in komplexe, geschmacksintensive Getränke.

🍵 Alkoholfreie fermentierte Getränke
Kombucha
Basis: Gesüßter Tee + SCOBY
Fermentation: 7-30 Tage
Geschmack: Säuerlich-spritzig
Wasserkefir
Basis: Zuckerwasser + Kristalle
Fermentation: 24-48 Stunden
Geschmack: Leicht süß, prickelnd
Jun
Basis: Grüner Tee + Honig + SCOBY
Fermentation: 5-7 Tage
Geschmack: Mild, blumig
Kwas / Brottrunk
Basis: Roggenbrot + Wasser
Fermentation: 2-5 Tage
Geschmack: Malzig, leicht sauer
Tepache (Mexiko)
Basis: Ananasschalen + Piloncillo
Fermentation: 2-3 Tage
Geschmack: Fruchtig, süß-sauer
Ginger Bug
Basis: Ingwer + Zucker + Wasser
Fermentation: 5-7 Tage Starter
Geschmack: Scharf, prickelnd
🍹 Starte deine eigene Getränke-Fermentation
🍺 Alkoholische fermentierte Getränke
Bier Wein Sake (Japan) Met (Honigwein) Cider / Apfelwein Pulque (Mexiko) Palm Wine (Afrika) Chicha (Südamerika)
Fermentierte Sojaprodukte
Asien ist die Heimat einiger der komplexesten Fermentationstechniken der Welt. Besonders die Fermentation von Soja hat dort eine jahrtausendealte Tradition und bringt einzigartige Geschmacks- und Nährstoffprofile hervor.

🇮🇩 Tempeh (Indonesien)
Fermentation: Rhizopus oligosporus (Schimmelpilz)
Dauer: 24-48 Stunden bei 30°C
Nährwert pro 100g:
- 19g Protein
- Vitamin B12 (durch Fermentation)
- Alle essentiellen Aminosäuren
- Leicht verdaulich
🇯🇵 Miso (Japan)
Fermentation: Aspergillus oryzae (Koji) + Bakterien
Dauer: 6 Monate bis 3 Jahre
Varianten:
- Shiro Miso (weiß, mild)
- Aka Miso (rot, kräftig)
- Hatcho Miso (dunkel, intensiv)
- Mugi Miso (mit Gerste)
🇯🇵 Nattō (Japan)
Fermentation: Bacillus subtilis
Dauer: 22-24 Stunden
Besonderheiten:
- Fädenziehend, stark riechend
- Reichste Quelle für Vitamin K2
- Enthält Nattokinase (Enzym)
- Traditionelles Frühstück
🇨🇳 Sojasauce
Fermentation: Aspergillus + Milchsäurebakterien
Dauer: 6-36 Monate (traditionell)
Varianten:
- Shoyu (Japan)
- Tamari (ohne Weizen)
- Kecap Manis (Indonesien, süß)
- Ganjang (Korea)
➕ Weitere fermentierte Sojaprodukte:
Doubanjiang (China) Douchi (China) Cheonggukjang (Korea) Tauchu (Thailand) Fermentierter Tofu Stinky Tofu (Taiwan)
„Tempeh ist der perfekte Einstieg in die Schimmelpilz-Fermentation. Im Gegensatz zu Miso oder Sojasauce, die Monate reifen müssen, ist Tempeh in nur 24-48 Stunden fertig. Bei HeldenPilz empfehlen wir Anfängern, mit Sojabohnen zu starten – sie sind am verzeihendsten."
— HeldenPilz Team
Fermentierte Getreideprodukte
Die Fermentation von Getreide macht Nährstoffe besser verfügbar, baut Antinährstoffe wie Phytinsäure ab und erzeugt einzigartige Aromen. Sauerteigbrot ist das bekannteste Beispiel, aber es gibt viel mehr zu entdecken.
🍞 Sauerteigbrot
Kulturen: Wilde Hefen + Lactobacillus
Vorteile: Niedriger glykämischer Index, besser verträglich
🇯🇵 Koji / Amazake
Kulturen: Aspergillus oryzae
Verwendung: Süßungsmittel, Basis für Sake, Miso
🇮🇳 Idli & Dosa
Basis: Reis + Linsen, fermentiert
Vorteile: Proteinreich, leicht verdaulich
🇪🇹 Injera (Äthiopien)
Basis: Teffmehl, 2-3 Tage fermentiert
Vorteile: Glutenfrei, schwammartige Textur
➕ Weitere fermentierte Getreideprodukte:
Ogi (Nigeria) Pozol (Mexiko) Boza (Türkei) Kishk (Naher Osten) Rejuvelac Fermentierter Hafer
Fermentierte Spezialitäten weltweit
Jede Kultur hat ihre eigenen fermentierten Spezialitäten entwickelt – von fermentiertem Fisch in Skandinavien bis zu fermentierten Hülsenfrüchten in Afrika. Hier ein Blick auf die globale Vielfalt der Fermentation:
🇪🇺 Europa
- Surströmming (Schweden) – Fermentierter Hering
- Rakfisk (Norwegen) – Fermentierte Forelle
- Käse – Roquefort, Camembert, Gouda
- Wurst – Salami, Chorizo, Mettwurst
🌏 Asien
- Fish Sauce (Vietnam/Thailand) – Fermentierte Fischsauce
- Bagoong (Philippinen) – Fermentierte Garnelen
- Atchara (Philippinen) – Fermentierte Papaya
- Shrimp Paste – Verschiedene asiatische Varianten
🌍 Afrika
- Dawadawa (Westafrika) – Fermentierte Johannisbrotbaumsamen
- Garri (Nigeria) – Fermentierter Maniok
- Mageu (Südafrika) – Fermentierter Maisbrei
- Iru – Fermentierte Hülsenfrüchte
🌎 Amerika
- Hot Sauce (Louisiana) – Fermentierte Chili-Sauce
- Ceviche (Peru) – Zitrus-fermentierter Fisch
- Chicha (Anden) – Fermentiertes Maisgetränk
- Sauerkraut (USA) – Deutsche Einwanderer-Tradition
Fermentierte Lebensmittel selber machen
Die gute Nachricht: Du kannst viele fermentierte Lebensmittel ganz einfach zu Hause herstellen. Hier ist unser Empfehlungs-Guide für Einsteiger:
Anfänger
- Sauerkraut
- Salzgurken
- Wasserkefir
- Fermentierte Möhren
Fortgeschritten
- Kombucha
- Milchkefir
- Kimchi
- Joghurt
Experte
- Tempeh
- Miso
- Koji
- Nattō
🌿 Unterstütze deine Darmgesundheit zusätzlich
Neben fermentierten Lebensmitteln können hochwertige Nahrungsergänzungsmittel deine Darmflora unterstützen:
💡 5 goldene Regeln für erfolgreiche Fermentation
- Sauberkeit: Saubere Hände und Gefäße, aber nicht steril – gute Bakterien brauchen eine Chance
- Salz: Bei Gemüse 2-3% Salz zum Gewicht – hemmt schädliche Bakterien
- Unter der Lake: Gemüse muss vollständig von Flüssigkeit bedeckt sein
- Temperatur: Die meisten Fermente mögen 18-24°C – nicht zu warm, nicht zu kalt
- Geduld: Gib den Mikroorganismen Zeit – gute Fermentation braucht Zeit
Häufige Fragen zu fermentierten Lebensmitteln
Sind alle fermentierten Lebensmittel probiotisch?
Nein, nicht alle. Nur unpasteurisierte fermentierte Lebensmittel enthalten lebende Kulturen. Industriell hergestelltes Sauerkraut oder Joghurt wird oft pasteurisiert, was die probiotischen Bakterien abtötet. Achte auf Hinweise wie "unpasteurisiert" oder "mit lebenden Kulturen" auf der Verpackung, oder stelle deine fermentierten Lebensmittel selbst her.
Wie viel fermentierte Lebensmittel sollte ich täglich essen?
Eine allgemeine Empfehlung sind 1-2 Portionen pro Tag, z.B. 100g Sauerkraut, 200ml Kefir oder eine kleine Schale Kimchi. Wenn du neu in der Welt fermentierter Lebensmittel bist, starte langsam mit kleinen Mengen und steigere dich – dein Darm braucht Zeit, sich an die neuen Bakterien zu gewöhnen.
Können fermentierte Lebensmittel schlecht werden?
Ja, aber sie sind durch die Fermentation deutlich länger haltbar als frische Lebensmittel. Anzeichen für Verderb: Schimmel (nicht zu verwechseln mit Kahmhefe), fauliger Geruch, schleimige Textur. Im Zweifel gilt: Wenn es schlecht riecht oder aussieht, entsorge es. Korrekt fermentierte Lebensmittel riechen säuerlich, aber angenehm.
Sind fermentierte Lebensmittel für jeden geeignet?
Die meisten Menschen vertragen fermentierte Lebensmittel gut. Vorsicht ist geboten bei: Histaminintoleranz (viele Fermente enthalten Histamin), immunsupprimierten Personen, und in der Anfangsphase bei sehr empfindlichem Darm. Bei Unsicherheiten sprich mit deinem Arzt. Generell gilt: Langsam anfangen und die individuelle Verträglichkeit beobachten.
Was ist der Unterschied zwischen Fermentation und Einlegen?
Fermentation nutzt Mikroorganismen, die natürlich vorhandene Zucker umwandeln und dabei Säure produzieren. Einlegen (Pickling) verwendet zugesetzten Essig zur Konservierung. Der wichtige Unterschied: Fermentierte Lebensmittel enthalten lebende Kulturen und sind probiotisch, in Essig eingelegte nicht.
Fazit: Fermentation ist eine Reise
Die Welt der fermentierten Lebensmittel ist unglaublich vielfältig – von einfachem Sauerkraut bis zu komplexem Miso, von erfrischendem Wasserkefir bis zu proteinreichem Tempeh. Jede Kultur hat ihre eigenen Fermentations-Traditionen entwickelt, und alle teilen einen gemeinsamen Nenner: Die transformative Kraft der Mikroorganismen.
Der beste Weg, fermentierte Lebensmittel in deinen Alltag zu integrieren: Fang klein an. Probiere verschiedene Fermente, finde deine Favoriten und wage dich vielleicht sogar ans Selbermachen. Dein Darm wird es dir danken.
Bereit für deine Fermentations-Reise?
Entdecke unsere Starterkulturen und beginne noch heute mit der Herstellung deiner eigenen fermentierten Lebensmittel.